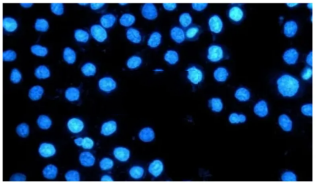
6.png

一、免疫荧光常用染料
1. FITC(异硫氰酸荧光素)
①激发波长490nm,发射波长525nm,绿色荧光在常规显微镜下清晰可见。
②价格低,标记效率高,但光稳定性差,曝光时间超过30秒易出现信号衰减。
【注意事项】FITC在酸性环境下荧光强度下降,因此固定细胞时需用PBS彻底冲洗。

2. TRITC(四甲基罗丹明异硫氰酸酯)
①激发波长557nm,发射波长576nm,红色荧光,常与FITC搭配做双标实验。
②分子量比FITC大,对抗体活性影响更明显,建议抗体浓度不低于5ug/ml。
【注意事项】遇到背景偏高时,用1%BSA封闭能减少非特异性吸附。

3. Cy系列(Cy3、Cy5、Cy7)
①Cy3:激发波长550,发射波长570nm,橙红色荧光,亮度高,但光稳定性较差。
②Cy5:激发波长649nm,发射波长576nm,远红外荧光,穿透力强,需共聚焦显微镜检测。
③Cy7:激发波长743nm,发射波长767nm,近红外荧光,适用于活体实验。

4. Alexa Fluor系列染料(AF488绿色、AF555橙红色、AF647远红等)
①光稳定性比传统染料强3~5倍,适合长时间动态观察。
②光谱间距优化(25~30nm),串扰低(<5%),pH耐受范围广(pH4-10)。
【注意事项】AF647发射波长在近红外区,普通显微镜需更换滤光片组。

5. DAPI(4’,6-二脒基-2-苯基吲哚)
①专染细胞核,激发波长358nm,蓝色荧光,需配备紫外光源。
②能穿透活细胞膜,但浓度超过1ug/mL会产生细胞毒性。
【注意事项】做活细胞成像时建议改用Hoechst 33342,该染料激发波长更接近可见光范围,对细胞损伤较小。

6. Hoechst
①激发波长355nm,发射波长461nm,蓝色荧光,可以穿透细胞膜对细胞核内DNA染色。
②溶于水和有机溶液,荧光强度随溶液pH升高而增强。
③毒性低,适用于活细胞核染色。
7. PI(碘化丙啶)
①激发波长538nm,红色荧光,能够与DNA强力结合。
②嵌入双链DNA后释放红色荧光,实现对DNA或细胞核的染色。不能通过活细胞膜,仅标记死细胞DNA,用于细胞活力检测。

8. CF系列(CF350蓝色、CF488A绿色、CF647远红等)
①水溶性极好,非特异性结合少,光稳定性强,量子产率高。
②适用于长时间成像和高信噪比实验。
二、如何根据需求选择染料
1、实验类型
单标:传统染料(FITC)或高亮度染料(AF488)。
多标:光谱无重叠的染料组合(如AF488+AF555+AF647)优先选Alexa Fluor或CF系列减少串扰。
2、样本类型
固定样本:Alexa Fluor或CF系列。
活体/活细胞:近红外染料(Cy7、CF790)减少自发荧光干扰或Hoechst。
3、信号强度与背景控制
低丰度靶标:高量子产率染料(AF555、CF568)。
高背景样本:CF系列(非特异性结合少)。
4、成本与实验周期
预算有限:传统染料(FITC、TRITC)。
长期成像:必选 Alexa Fluor或CF系列抵抗光漂白。
实验外包 想了解更多请关注:http://www.do-gene.cn

